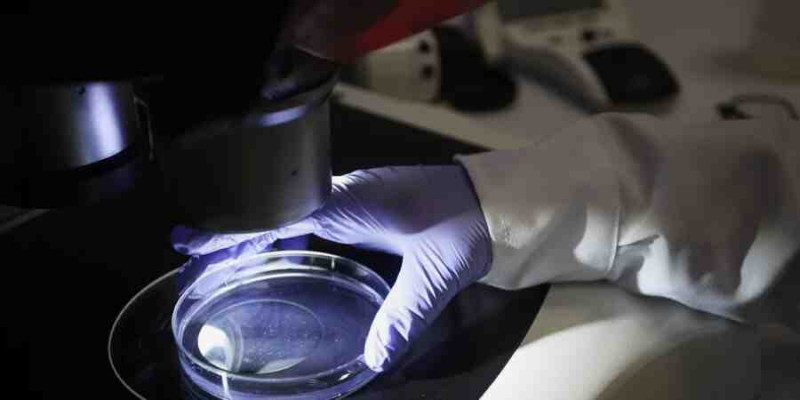
На Украине сотрудница биолаборатории выкрала флаконы со штаммами опасного вируса

На Украине научная сотрудница украла из лаборатории штамм опасного вируса с целью продажи.

Генпрокуратура Украины сообщила, что женщина работала заведующей одним из секторов в Государственном научно-контрольном институте биотехнологий и штаммов. При этом, она похитила флаконы со штаммом вируса ньюкаслской болезни птицы, который считается особенно опасным, и вынесла из лаборатории. Отмечается, что похищенный вирус способен быстро распостраняться на больших территориях независимо от государственных границ.
Похитительница умышленно уменьшала количество исходных образцов, не возвращала их в хранилище микроорганизмов, а также присваивала часть новосозданного материала. Украденные образцы женщина хранила у себя дома в холодильнике и собиралась продать.
Ранее сообщалось, что США построили на Украине целую сеть лабораторий, где хранят особо опасные инфекции, якобы чтобы предотвратить создание биологического оружия.
Москва неоднократно выражала тревогу по поводу деятельности таких учреждений в непосредственной близости от границ РФ. Российские власти полагают, что Украина и США пытаются скрыть истинное содержание и направленность деятельности биолабораторий, тем более что в районах, где они расположены, наблюдается пугающая ситуация с заболеваемостью местных жителей.
Ньюкаслская болезнь птиц — остро протекающее и быстро распространяющееся вирусное заболевание, при котором у птиц поражаются органы дыхания и центральная нервная система, что может привести к их массовому падежу.


